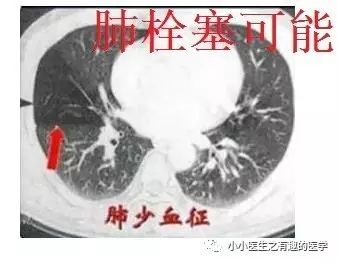
ct平扫肺部能查出是哮喘吗,ct平扫肺结节准确吗

不想错过界哥的推送?
戳上方蓝字“医学界呼吸频道”关注我们
关注我们并点击右上角“···”菜单,选择“设为星标”

让我们通过病例来学习如何通过胸部CT来发现和诊断肺栓塞。
胸部高分辨CT平扫,可发现肺栓塞,甚至国外有高手在某些情况下直接拿来诊断肺栓塞。哎,看世界纷纷扰扰,刀光剑影,高手出招,总让人耳目一新。
今天把近期整理的文献和大家分享,期望与大家一起探讨。先上病例,我喜欢在病例分析中学习。
病例一
作者单位:Department of Radiology, Thoracic Imaging Section, San Francisco General Hospital(旧金山总医院)。

如图,高密度影的那一条。
不怕,有增强CT证实。

是不是很有趣。
再来一个图。

仔细看,有端倪。
增强CT可以核实。

很明显,患者做了CT平扫,我们要仔细阅片,发现可疑,及时增强CT,要不然就漏诊了。
上面图片的英文原版
↓↓↓

病例二
作者单位:Department of Radiology, University of Washington MedicalCenter, University of Washington School of Medicine(华盛顿医科大学)。
翠花上菜,学者上图。

发现嫌疑犯,立即逮捕。

增强CT对比,一目了然。

上面的患者,增强CT放大了。
下面是另外一个
↓↓↓

星号的地方。

再来一个

很明显:扯蛋肺栓塞。

没看够?
再来一个,让你一次看个够。

不光是肺栓塞,连主动脉夹层,都发现了。
牛。我来标记一下。

究竟是美国的设备好,还是他们认真仔细?两者相辅相成。生产工具很重要,人的努力也很重要。
另外,社会要和谐。
老外报道一例患者,门诊急诊CT平扫发现肺栓塞,但是患者危重,再次外出做增强CT很危险,别人直接高分辨CT诊断肺栓塞,直接治疗,病情缓解再出去检查。在中国,你懂的(抱歉:有些文献*载下**要钱,穷,没有*载下**到)。
病例三:
其实,我大中华也有医生用CT平扫发现可疑肺栓塞。
下面是上海交通大学的论文
↓↓↓

基本上看得到。
病例四:
再介绍一位牛人:首都医科大学,附属北京友谊医院,放射科主任医师,李铁一教授。以前买过一本他的书。当时在读研究生,刚好有点钱,就买了,可惜书太老,图像不清楚,但书写得很好。
2004年,李铁一教授就说了:对于不能使用对比剂或因非典型心肺症状而仅作平扫的病例,肺动脉CT平扫的异常密度改变能提示急性肺动脉栓塞的存在。

中国的扫描仪质量有待提高,各位意会一下。
文献五
国外有高手专门研究了CT平扫诊断肺栓塞的可靠程度。
高分辨CT平扫管腔内高密度征象诊断肺栓塞的敏感性36.0%, 特异性99.0%,阳性预测值90.0%,阴性预测值85.6% 。
高分辨CT平扫管腔内高密度征象诊断中心肺栓塞敏感性66.7%, 特异性99.1%。
另外,CT发现肺纹理减少,也要警惕肺栓塞。先来说说马赛克。
马赛克征象:由于气道疾病或肺血管性疾病,引起相邻的肺区血液灌注上的差别而出现的不均匀肺密度区,称马赛克灌注。
以图说话,下面都是马赛克,注意了
↓↓↓

马赛克是什么意思,
就是马赛克存在的意义?
如图:

假如CT平扫发现肺部某些地方血管稀疏,灌注不足,千万不要以为没事,有时候,就是肺栓塞,需要警惕。
马赛克,需要警惕肺栓塞,它是肺栓塞的间接表现。并且,在临床中,间断会遇到这样的情况。
至于典型的“倒三角”要考虑肺栓塞,这些太经典,我就不赘述。

参考文献:
1.Gotway M B, Webb W R. Acute pulmonary embolism: visualization of high attenuation clot in the pulmonary artery on noncontrast helical chest CT[J]. Emergency Radiology, 2000, 7(2):117-119.
2.Kanne J P, Gotway M B, Thoongsuwan N, et al. Six cases of acute central pulmonary embolism revealed on unenhanced multidetector CT of the chest.[J]. Ajr American Journal of Roentgenology, 2003, 180(6):1661-4.
3.吴世明, 陈龙兴, 唐震. CT平扫在急性肺栓塞中的诊断意义[J]. 医学影像学杂志, 2017, 27(4):652-655.
4.李辉, 李铁一, 郝晓光. 值得注意的急性肺动脉栓塞平扫CT征象[J]. 中华放射学杂志, 2004, 38(11):1169-1172.
5.Tatco V R, Piedad H H. The validity of hyperdense lumen sign in non-contrast chest CT scans in the detection of pulmonary thromboembolism[J]. International Journal of Cardiovascular Imaging, 2011, 27(3):433-440.
本文首发:小小医生之有趣的医学
本文作者:云南省一院 孙丹雄
责任编辑:董小雯
版权声明
本文转载 欢迎转发朋友圈
- End -
觉得好看,请点这里
↓↓↓↓